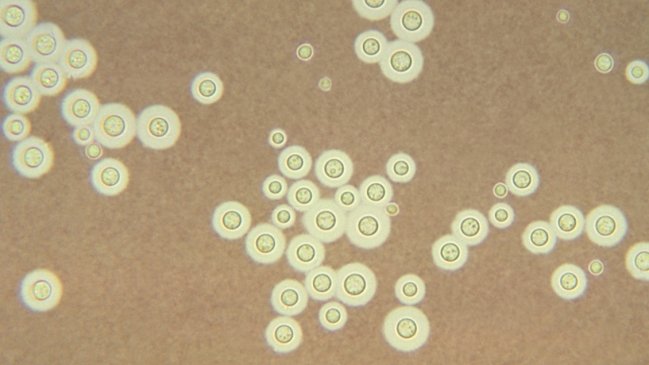
OMS publicó lista de hongos más peligrosos: 14 están presentes en Chile

La OMS publicó una lista de los 19 hongos más peligrosos, los que causan la muerte de más de 1,6 millones de personas al año, 14 de los cuales están presentes en nuestro país.
Eduardo Álvarez, investigador del Instituto de Ciencias Biomédicas de la Universidad de Chile, comentó que "esta lista prioritaria de hongos de importancia médica es crucial para el mundo y, por supuesto, para nuestro país. Por primera vez en la historia, se coloca el foco en hongos que causan una serie de enfermedades, muchas veces silentes".
"El número real de estas infecciones en Chile es desconocido, por lo que el real impacto a nivel local no se conoce con certeza. De hecho, el único esfuerzo nacional fue realizado junto a GAFFI el año 2017, donde estimamos que alrededor de 350.000 chilenos al año sufren de una micosis potencialmente letal", recalcó.
Dos de las especies de hongos encontradas recientemente en Chile corresponden a micosis importadas desde zonas tropicales y subtropicales: Candida auris (categorizado como crítico) e Histoplasma capsulatum.
Respecto a esta última especie, Álvarez advirtió que "ya hemos diagnosticado cerca de 40 casos de esta micosis importada. Candida auris, en tanto, apareció hace un par de años en nuestro país y ha generado alarma por su alta resistencia a los antifúngicos y a compuestos que se ocupan como desinfectantes ambientales. Esta capacidad le ha permitido instalarse en ambientes intrahospitalarios y provocar brotes".
La lista elaborada por la OMS tiene como objetivo impulsar nuevas investigaciones e intervenciones políticas tendientes a reforzar la respuesta mundial a las infecciones fúngicas graves, colocando especial atención a la resistencia a los antifúngicos.
"Afortunadamente, en Chile tenemos un sistema de diagnóstico de las micosis bien implementado, lo que nos permite realizar diagnósticos certeros y rápidos. Esto contribuye enormemente a la proyección exitosa de la infección en los pacientes, disminuyendo la letalidad. Este sistema evidentemente funciona bien en grandes ciudades, pero posiblemente aún falte en las ciudades más pequeñas o extremas", valoró el experto.